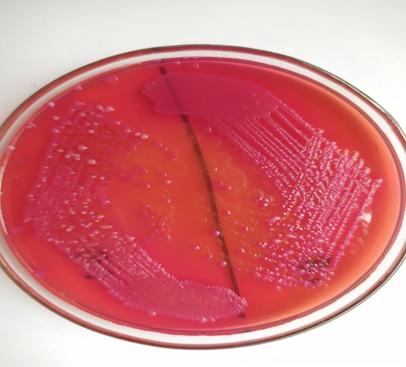
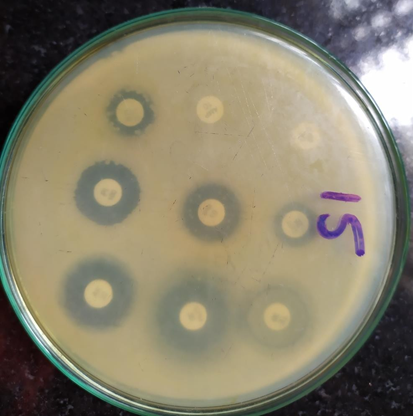

Int J Curr Pharm Res, Vol 15, Issue 1, 19-21Original Article
ISOLATION OF MULTI DRUG RESISTANT BACTERIA FROM BORE WATER SAMPLES IN AND AROUND VISAKHAPATNAM
TIRUVAIPATI SIRISHA1, SWAPNA SASAPU2, PAYALA VIJAYALAKSHMI3, PILLI HEMA PRAKASH KUMARI4*
1Department of Microbiology, Government Medical College, Srikakulam Dist, Andhra Pradesh, India, 2Department of Microbiology, Andhra Medical College, Visakhapatnam, 3,4*Department of Microbiology, GITAM Institute of Medical Sciences and Research, GITAM (Deemed to be University), Visakhapatnam 530045, Andhra Pradesh, India
Email: hemaprakashpilli@gmail.com
Received: 06 Jan 2023, Revised and Accepted: 17 Feb 2023
ABSTRACT
Objective: The aim of the present study was to determine the levels of groundwater contamination by isolating total coliforms, fecal coliforms, and bacterial pathogens.
Methods: A total of 32 water samples, comprising 5 samples from each GVMC urban area zone, Visakhapatnam were randomly collected from different areas. Evaluation of Total and fecal coliform counts was done by using multiple-tube fermentation technique and were reported as the most probable number (MPN) of organisms present per 100 ml of sample.
Results: The samples collected from the zones Yendada (zone I), Marripalem (zone IV), Chinna musidiwada (zone VI) showed the highest total and fecal coliform counts (MPN>180). Nearly 30 samples (94%) yielded bacterial isolates. Among the isolates Pseudomonas spp. showed highest susceptibility to cefepime and imipenem antibiotics. All the microorganisms isolated were multidrug resistant with a multidrug antibiotic resistant index more than 0.2.
Conclusion: These multidrug-resistant (MDR) organisms are considered as a major threat to the public health and should receive more attention.
Keywords: MDR microorganisms, MPN, Water-borne diseases, Antibiotics
© 2023 The Authors. Published by Innovare Academic Sciences Pvt Ltd. This is an open access article under the CC BY license (https://creativecommons.org/licenses/by/4.0/)
DOI: https://dx.doi.org/10.22159/ijcpr.2023v15i2.2083 Journal homepage: https://innovareacademics.in/journals/index.php/ijcpr
INTRODUCTION
Water is an incredibly basic natural requirement for life. However, access to potable water has been an age old challenge because of the rising human populations and activities, which are in no small measure impacting negatively on the chemical and microbiological qualities of available water supplies. As a result of rising human population there is water scarcity and inaccessibility of potable water to people. To address this demand, groundwater is increasingly used as a water source globally. From the beginning of the twentieth century, there was an increase in the industrialization, urbanization, and population which leads to a rise in the use of natural resources and contributed to the emergence of the problems like environmental pollution and poses health problems to the human life. Disposal of increased quantities and varied contents of both solid and liquid wastes into the environment causes an air and water pollution [1]. The major pathogenic bacteria which potentially transmitted through water ingestion include Escherichia coli, Klebsiella species, Salmonella enterica subspecies, Enterica Serovar typhi, Salmonella enterica subsp. Enterica Serovar Paratyphi, Shigella species, Vibrio cholerae, Acinetobacter species, Clostridium species and Bacillus anthracis. Other bacterial pathogens that can survive in soil and water include Legionella species, Burkholderia pseudomallei and atypical mycobacteria [2-4]. Since 1895, E. coli has been identified as an indicator of fecal pollution in water samples; not all species of E. coli are pathogenic, but a few of these bacteria, such as E. coli O157:H7, can be fatal [5, 6]. The most probable number technique is commonly used as an index to determine the microbial safety of drinking water; this method is performed in multiple tubes showing the probabilistic value of the bacteria in 100 ml of water, as described in ISO 6461 [7]. Untreated waste introduces additional resistant bacteria into water, likely also constituting an important mechanism for the dissemination of antibiotic-resistant bacteria (ARBs) in natural bacterial communities. ARBs are becoming a major global public health problem (Bush et al. 2011; Port et al. 2014), and the extensive use of antimicrobial treatments in humans and animals may increase resistant bacteria populations in the aquatic environment [8]. Over the past decades, much progress has been achieved on water supply, sanitation and hygiene according to World Health Organization report [9]. Finding solutions to these problems have been challenged by the current waves in multiple-drug resistance and production of extended spectrum beta-lactamases reportedly demonstrated by enteric bacteria [10]. Antibiotic-resistant genes conferring resistance to a wide variety of antibiotics have been identified in a large range of water environments including drinking water in both developed and developing countries [11, 12]. The main risk for public health is that resistance genes are transferred from environmental bacteria to human pathogens. The potential of drinking water to transport microbial pathogens to a greater number of people, causing subsequent illness, is well documented in countries at all levels of economic development [13]. Furthermore, the availability of safe drinking water is an indispensible feature for preventing epidemic disease and improving the quality of life. According to the World Health Organization, 80% of all diseases are attributed to unsafe water. Developing countries in particular, are plagued with water-related diseases such as diarrhea which account for 10% of the disease burden in such countries [14-16]. The gastrointestinal bacteria can be exposed to antibiotics at their source and their environment; hence develop drug resistance that finally ends up in water [17]. The aim of present study was to determine the levels of ground water contamination by isolating total coliforms, fecal coliforms, and bacterial pathogens. The other objectives of the study was to determine the antibiotic resistance to various antibiotics that are used in the treatment of bacterial infections and correlating antibiotic drug resistance among the isolated pathogens and assessing the probable cause.
MATERIALS AND METHODS
Collection of samples
Visakhapatnam has been divided into six zones by Greater Visakhapatnam Municipal Corporation. Six different zones situated in urban areas of Visakhapatnam, Andhra Pradesh, India. Borehole wells were one of the major water source used by the local inhabitants for the purpose of drinking, cooking or washing purposes. A total of 32 water samples, comprising 5 samples from each zone randomly collected from different areas, which include (Bheemli, MV Pcolony, Rushikonda, Madhurawada, Sagarnagar, Yendada, Akkayapalem, Kancharapalem, Gajuwaka, Seethamadhara, Maddilapalem, PM palem, Sheelanagar, Maharanipeta, Pendhurthi, Madhavadhara, Marripalem, Isakathota, Railway new colony, Allipuram, Bajji junction, Lawsens bay colony, Assilmetta, Zillaparishad, Chinnamushidiwada, Hanumanthwaka, BHPV, Steelplant, Kurmanapalem, NAD junction. The Geographical Coordinates are described for 32 samples sites in table 1, and each location was selected near principal urban settlements.100 ml of water samples are collected in a sterile glass bottle. All the water samples were well labeled and transported within 2 h to the Department of Microbiology Laboratory, GITAM Institute of Medical Sciences and research, GITAM, Deemed to be University campus located at Rushikonda, Visakhapatnam. The isolation, identification and confirmation of enteropathogenic bacteria were determined by using standard microbiological and biochemical techniques for the identification of Gram-negative bacteria from all collected sample points.
Table 1: Description of sample points and geographic coordinates of six zones of visakhapatnam
| Sample points | Geographic coordinates | |||
| Sample | Zone | Samplesite | North | East |
| I | Bheeminipatnam | 17.9287 | 83.4266 | |
| I | Yendada | 17.7751 | 83.3633 | |
| I | Hanumanthuwaka | 17.7618 | 83.3069 | |
| I | Madhurawada | 17.8243 | 83.3564 | |
| I | PM Palem | 17.7996 | 83.3531 | |
| I | PedaRushikonda | 17.7925 | 83.3842 | |
| II | Lawson’sbaycolony | 17.7328 | 83.3369 | |
| II | Sivajipalem | 17.7355 | 83.3275 | |
| II | Seethammadhara | 17.7432 | 83.3145 | |
| II | Akkayyapalem | 17.7353 | 83.3000 | |
| II | MVPColony | 17.7413 | 83.3345 | |
| III | Allipuram | 17.7163 | 83.2955 | |
| III | Adharshnagar | 17.7413 | 83.3248 | |
| III | Daspalla | 17.7107 | 83.3135 | |
| III | Railwayquarters | 17.7218 | 83.2947 | |
| III | Asilametta | 17.7262 | 83.3155 | |
| IV | Muralinagar | 17.7472 | 83.2626 | |
| IV | Madhavadhara | 17.7486 | 83.2582 | |
| IV | Marripalem | 17.7401 | 83.2519 | |
| IV | RailwayNew colony | 17.7278 | 83.2974 | |
| IV | Narasimhanagar | 17.7377 | 83.2957 | |
| IV | Kancharapalem | 17.7358 | 83.2733 | |
| V | SteelPlant | 17.6346 | 83.1971 | |
| V | Sheelanagar | 17.7170 | 83.1956 | |
| V | Kurmannapalem | 17.6906 | 83.1664 | |
| V | BHPV | 17.7023 | 83.2010 | |
| V | Gajuwaka | 17.6851 | 83.2035 | |
| V | Bajijunction | 17.7439 | 83.2278 | |
| VI | Chinnamushidiwada | 17.8024 | 83.2048 | |
| VI | Vimanagar | 17.7447 | 83.2319 | |
| VI | Gopalapatnam | 17.7480 | 83.2179 | |
| VI | Penduthi | 17.8221 | 83.2051 | |
Microbiological analysis
Determination of total/Fecal coliform
Evaluation of Total and fecal coliform counts was done by using multiple-tube fermentation technique and were reported as the most probable number (MPN) of organisms present per 100 ml of sample. The MPN analysis was performed according to the Mackie and Mac-Cartney biochemical standards. 10 ml and 1 ml aliquots of the site samples were inoculated in the number of five tubes containing double-strength Mac Conkey broth containing inverted Durham tubes and incubated at 37C for 24 h. 1 ml of gas-positive samples are inoculated into 10 ml of Double Strength of Mac Conkey broth and incubated at 44 °C. Another milliliter of the gas-positive sample was inoculated in brilliant green broth for fecal coliform Confirmation and was incubated at 37 °C. The negative samples were incubated for an additional 48 h have a confirmative test [18].
Isolation of microbial pathogens
Water samples are analyzed using standard microbiological techniques for the enumeration of bacteria and the identification of pathogens. To isolate pure cultures, the samples which turned into yellow color from red color of Mac Conkey broth (fig. 1) and the samples which has air bubbles collected are inoculated into Mac Conkey Agar (fig. 2). From the initial bacterial growth, pure culture isolates were separated and analyzed further through macroscopic and microscopic characterizations. Each isolate was characterized based on its colony macroscopic morphology (shape, size, and type of edge, transmitted or reflected light) and Gram stain.
Biochemical identification
Pure colonies were recovered from Mac Conkey agar for biochemical identification to identify fermentative and non-fermentative Gram-negative bacilli. Identification was based on the detection analysis of biochemical tests. Following Culture methods, biochemical tests are often required to identify pathogens by using substrates and sugars to detect their enzymatic and fermentation reactions. The tests include carbohydrate fermentation tests with glucose, lactose, sucrose, xylose, mannitol and maltose etc. The organisms were also tested for Indole production, Methyl red test, Voges-Proskauer test, Citrate utilization, Urease test, Oxidase test, Catalase test, Nitrate reduction test, Triple sugar iron agar test etc [19, 20]. Identification of the pure culture was tested for Antimicrobial susceptibility testing as per CLSI standards and the antibiotic resistance profile is generated.

Fig. 1: MPN tubes showing changing of color due to fermentation of double strength MacConkey medium by pathogens
Fig. 2: Mac conkey agar showing lactose fermenting colonies and non-lactose fermenting colonies
Determination of antibiotic resistance
Disc diffusion refers to the diffusion of an antimicrobial agent of a specified concentration from discs or strips into the solid culture medium that has been seeded with the selected inoculum isolated in a pure culture. Disk diffusion is based on the determination of an inhibition zone proportional to the bacterial susceptibility to the antimicrobial present in the disk. The diffusion of the antimicrobial agent into the seeded culture media results in a gradient of the antimicrobial. AST was performed according to CLSI guidelines using Mueller-Hinton agar (MHA) plates using the concentration of antibiotics per discs (fig. 4), recommended by the WHO experts committee on biological standardization (fig. 3). The plates were incubated at 37 °C for 16-18h. The antibiotic discs used in this study were Piperacillin(100µg), Amikacin (30µg), Gentamicin (10µg), Ceftazidime (30µg), Ciprofloxacin (5µg), Imipenem (10µg), Ampicillin/Sulbactum (10/10 µg), Colistin E strips, Ampicillin (10 µg), Amoxyclav (20/10µg), Co-trimoxazole (25µg), Cefepime (30µg), Cefuroxime (30µg), Ceftazidime/Clavulanic acid (30/10 µg), Nitrofurantoin (300 µg), Tetracycline (30 µg). The inhibition zone was measured according to CLSI guidelines (CLSI Catalogue, 2016) [20].
Statistical analysis
Data were statistically analyzed using SPPS software version 24.0. Frequency and percentages were calculated for categorical and ordinal variables. Fischer’s test was carried out and p-value ≤ 0.05 were considered statistically significant.
Fig. 3: Antibiotic susceptibility testing as per CLSI guidelines
RESULTS
Microbiological analysis
The samples collected from the six different zones involving 32 sampling points were analyzed for total and fecal coliform counts. The total coliform counts from the sampling points are shown in fig. 4. The samples collected from the zones Yendada (zone I), Marripalem (zoneIV), Chinnamusidiwada (zoneVI) showed the highest total and fecal coliform counts (MPN>180) compared with the other sample sites. At the same time, Asilametta comes under zone IV also showed a potential MPN count (MPN>92). At the same time the sample points like Madhurawada (zone I) and Sivajipalem (zone II) showed no or very less counts of fecal coliforms (MPNcount1-2). Table 2 depicted the different organisms isolated from the 32 sampling points. Majority of the microorganisms isolated are E. coli, Proteus species and Pseudomonas species. The organisms were identified based on the morphological, cultural and biochemical characteristics.
Table 2: Microbial isolates from the borehole water samples
| Organism isolated | MPN | ||||
| N | Minimum | Maximum | Mean | SD | |
| Ecoli | 8 | 3 | 180 | 34.75 | 59.17 |
| Enterobacter species | 3 | 3 | 35 | 16.67 | 16.50 |
| Klebsiella species | 6 | 4 | 92 | 22.83 | 34.55 |
| Proteusspecies | 7 | 3 | 180 | 38.14 | 63.53 |
| Pseudomonas species | 8 | 2 | 180 | 27.13 | 61.87 |
| NoGrowth | 2 | 3 | 4 | 3.50 | 0.71 |

Fig. 4: Total coliform counts from the sampling sites
Out of 32 samples processed only 30 samples (94%) yielded bacterial isolates and the rest of 6% i.e. 2 samples had no bacterial growth. There are 32 isolates from 30 samples. Out of which majority of the organisms belonged to the family Enterobacteiaceae are Escherichia coli, Enterobacter species, Klebsiella species and Proteus species (75%) and the rest of 25% belonged to Pseudomonas species.
Determination of Antibiotic susceptibility
The antimicrobial susceptibility pattern of isolated microorganisms screened from the six zones from 32 sampling points was depicted from Tables 3 to table 7. Pseudomonas species showed the highest sensitivity to the antibiotics like cefepime and imipenem. Non-fermenting isolate showed sensitivity to cefepime and amikacin and Pseudomonas species showed the highest sensitivity to the antibiotics like cefepime and imipenem. Klebsiella species showed maximum sensitivity to amikacin, cefepime and imipenem, whereas Proteus species showed susceptibility to ceftazidime/clavulanic acid. Enterobacter species showed sensitivity to imipenem and amikacin (fig. 3). Multiple antibiotic resistance (MAR) index is calculated as the ratio of the number of antibiotics to which organisms is resistant to total number of antibiotics to which organisms is exposed. MAR Index = a/b. MAR index values greater than 0.2 indicate a high risk source of contamination where antibiotics are often used (32). All the isolates MAR index values are greater than 0.2 indicating that all the isolates from the bore water samples are multidrug-resistant and also indicate that the source of contamination has high usage of antibiotics (fig. 5).
Table 3: Antimicrobial susceptibility testing of pseudomonas species
| Pseudomonas species | Resistance | Sensitivity | ||
| Count | % | Count | % | |
| AMP | 7 | 87.5 | 1 | 12.5 |
| PI | 5 | 62.5 | 3 | 37.5 |
| CXM | 8 | 100.0 | 0 | 0.0 |
| CTX | 8 | 100.0 | 0 | 0.0 |
| CEC | 8 | 100.0 | 0 | 0.0 |
| CAZ | 8 | 100.0 | 0 | 0.0 |
| CPM | 0 | 0.0 | 8 | 100.0 |
| IMP | 1 | 12.5 | 7 | 87.5 |
| AK | 7 | 87.5 | 1 | 12.5 |
| COT | 8 | 100.0 | 0 | 0.0 |
| TE | 7 | 87.5 | 1 | 12.5 |
| P-value=<0.01* | ||||
Table 4: Antimicrobial susceptibility testing of E. coli
| E. coli | Resistance | Sensitivity | ||
| Count | % | Count | % | |
| AMP | 7 | 87.5 | 1 | 12.5 |
| PI | 6 | 75.0 | 2 | 25.0 |
| CXM | 8 | 100.0 | 0 | 0.0 |
| CTX | 7 | 87.5 | 1 | 12.5 |
| CEC | 7 | 87.5 | 1 | 12.5 |
| CAZ | 8 | 100.0 | 0 | 0.0 |
| CPM | 0 | 0.0 | 8 | 100.0 |
| IMP | 0 | 0.0 | 8 | 100.0 |
| AK | 2 | 25.0 | 6 | 75.0 |
| COT | 4 | 57.1 | 3 | 42.9 |
| TE | 7 | 87.5 | 1 | 12.5 |
| P-value=<0.01* | ||||
Table 5: Antimicrobial susceptibility testing of Klebsiella species
| Klebsiella species | Resistance | Sensitivity | ||
| Count | % | Count | % | |
| AMP | 4 | 66.7 | 2 | 33.3 |
| PI | 4 | 80.0 | 1 | 20.0 |
| CXM | 6 | 100.0 | 0 | 0.0 |
| CTX | 6 | 100.0 | 0 | 0.0 |
| CEC | 5 | 83.3 | 1 | 16.7 |
| CAZ | 6 | 100.0 | 0 | 0.0 |
| CPM | 2 | 33.3 | 4 | 66.7 |
| IMP | 0 | 0.0 | 6 | 100.0 |
| AK | 2 | 33.3 | 4 | 66.7 |
| COT | 3 | 50.0 | 3 | 50.0 |
| TE | 6 | 100.0 | 0 | 0.0 |
| P-value=<0.01* | ||||
Table 6: Antimicrobial susceptibility testing of proteus species
Proteus Species |
Resistance | Sensitivity | ||
| Count | % | Count | % | |
| AMP | 7 | 100.0 | 0 | 0.0 |
| PI | 7 | 100.0 | 0 | 0.0 |
| CXM | 7 | 100.0 | 0 | 0.0 |
| CTX | 7 | 100.0 | 0 | 0.0 |
| CEC | 5 | 71.4 | 2 | 28.6 |
| CAZ | 7 | 100.0 | 0 | 0.0 |
| CPM | 1 | 14.3 | 6 | 85.7 |
| IMP | 0 | 0.0 | 7 | 100.0 |
| AK | 2 | 28.6 | 5 | 71.4 |
| COT | 5 | 71.4 | 2 | 28.6 |
| TE | 7 | 100.0 | 0 | 0.0 |
| P-value=<0.01* | ||||
Table 7: Antimicrobial susceptibility testing of Enterobacter species
| Enterobacter species | Resistance | Sensitivity | ||
| Count | % | Count | % | |
| AMP | 3 | 100.0 | 0 | 0.0 |
| PI | 2 | 66.7 | 1 | 33.3 |
| CXM | 3 | 100.0 | 0 | 0.0 |
| CTX | 3 | 100.0 | 0 | 0.0 |
| CEC | 3 | 100.0 | 0 | 0.0 |
| CAZ | 3 | 100.0 | 0 | 0.0 |
| CPM | 2 | 66.7 | 1 | 33.3 |
| IMP | 0 | 0.0 | 3 | 100.0 |
| AK | 0 | 0.0 | 3 | 100.0 |
| COT | 2 | 66.7 | 1 | 33.3 |
| E | 3 | 100.0 | 0 | 0.0 |
| P-value=<0.01* | ||||

Fig. 5: MAR index of the isolated pathogens from bore water sources
DISCUSSION
Ground water has been considered a safe source of potable water since the ages and till date a lot of people depend on it for drinking. But the quality of groundwater is deteriorating and it is of paramount importance to assess the quality regarding various parameters. The samples collected from the zones Yendada (zone I), Marripalem (zone IV), Chinnamusidiwada (zone VI) showed the highest total and fecal coliform counts (MPN>180) compared with the other sample sites. At the same time the sample points like Madhurawada (zone I) and Sivajipalem (zone II) showed no or very less counts of fecal coliforms (MPN count 1-2). The reason of these changes could be the dissolution of salts and minerals, which are present in soil due to rise in water table. Krupanidhi (1984) [21] reported similar trend in ground water of a typical hard rock terrain and pollution in village wells in Karnataka state. Antibiotic-resistant bacteria have become of increasing public health concern because of the emergence of multiple drug-resistant pathogens, such as E. coli and Salmonella species [22]. Therefore a high exposure to these pathogens coupled with the increasing incidences of antibiotic resistance among bacteria pose a serious health risk and a greater likelihood of an outbreak similar to outbreaks of diarrhea that occurred in rural areas of South Africa, Limpopo Province due to contaminated borehole water [23].
The differences in antibiotic strains of the various water sources could reflect the specific use of antibiotics around the specified source. The rising trend of resistance in all the isolates (total and faecal coliforms) from upstream to downstream affirms the fact that disposed antibiotics may have been washed down the water sources and accumulated downstream, especially during the rainy season accounting for the high resistance. The higher level of resistance to antibiotics among coliform of midstream and downstream sites of local urban communities of Visakhapatnam is worrisome since most inhabitants take a bath, wash clothes, and even disposed human sewage into water sources at midstream and downstream sites while some occupants and non-occupants use these water sources for drinking and/or domestic purposes. Indeed, the increasing prevalence of resistance in the isolates, especially, of the human origin, may have an important therapeutic implication that calls for caution in the indiscriminate use of antibiotics on humans. However in the present study majority of the microorganisms isolated are E. coli, Proteus species and Pseudomonas species which showed maximum sensitivity to cefipime, imipenem, ceftazidime/clavulanic acid and showed maximum resistance to ampicillin, cotrimaxazole, tetracycline, ceftrixazone etc.
Sandhu et al. (2016) [24] has found that 76% of the inpatients isolates contain a value more than 0.2. in her study, only 23 % has less than 0.2 index. The pathogens isolated from the bore water sources have 100% more than 0.2 MAR Index. This is worrying pattern and playing it role in the dissemination of antibiotic resistance to humans inhabited in the residential zones.
CONCLUSION
Out of 32 samples, 3 samples showed have>180 MPN units and one sample has 92 MPN and 25 samples have MPN units between 10–20 and the rest of three samples have MPN 25–50. 30 samples yielded bacterial isolates from 32 samples processed from bore waters. Out of 32 samples, 32 isolates were identified. All the microorganisms isolated were multidrug resistant with MAR ratio of more than 0.2. These MDR organisms are considered as a major threat to public health and should receive more attention.
FUNDING
Nil
AUTHORS CONTRIBUTIONS
All the authors have contributed equally.
CONFLICT OF INTERESTS
The authors declared No Conflict of interest
REFERENCES
-
Akturk S. Adana determination of microbial quality in water from Adana‐Tufanbeyli road line. Adana: Cukurova Universitesi; 2009.
-
Baquero F, Martinez JL, Canton R. Antibiotics and antibiotic resistance in water environments. Curr Opin Biotechnol. 2008;19(3):260-5. doi: 10.1016/j.copbio.2008.05.006, PMID 18534838.
-
Korzeniewska E, Korzeniewska A, Harnisz M. Antibiotic-resistant Escherichia coli in hospital and municipal sewage and their emission to the environment. Ecotoxicol Environ Saf. 2013;91:96-102. doi: 10.1016/j.ecoenv.2013.01.014, PMID 23433837.
-
WHO. Water supply, sanitation and hygiene development. In: Water sanitation and Health; 2015. Available: www.who.int/water_sanitation_health/ hygiene/en/.2017.
-
Edqvist L, Pedersen K. Antimicrobials as growth promoters: resistance to common sense. In: MacGarvin M, Stirling A, Keys J, Wynne B, Guedes Vaz S, editors. Late lessons from early warnings: the precautionary principle 1896-2000; Harremoes P, Gee D. Copenhagen, Denmark: European Environmental Agency; 2001. p. 93-100.
-
Brown MG, Balkwill DL. Antibiotic resistance in bacteria isolated from the deep terrestrial subsurface. Microb Ecol. 2009;57(3):484-93. doi: 10.1007/s00248-008-9431-6, PMID 18677528.
-
Ellis H, Schoenberger E. On the identification of associations between five world health organization water, sanitation and hygiene phenotypes and six predictors in low and middle-income countries. PLOS ONE. 2017;12(1):e0170451. doi: 10.1371/journal.pone.0170451, PMID 28125625.
-
Bush K, Courvalin P, Dantas G, Davies J, Eisenstein B, Huovinen P. Tackling antibiotic resistance. Nat Rev Microbiol. 2011;9(12):894-6. doi: 10.1038/nrmicro2693, PMID 22048738.
-
Port JA, Cullen AC, Wallace JC, Smith MN, Faustman EM. Metagenomic frameworks for monitoring antibiotic resistance in aquatic environments. Environ Health Perspect. 2014;122(3):222-8. doi: 10.1289/ehp.1307009, PMID 24334622.
-
Munir M, Wong K, Xagoraraki I. Release of antibiotic-resistant bacteria and genes in the effluent and biosolids of five wastewater utilities in Michigan. Water Res. 2011;45(2):681-93. doi: 10.1016/j.watres.2010.08.033, PMID 20850863.
-
Samie A, Makonto TE, Odiyo J, Ouaboi-Egbenni PO, Mojapelo P, Bessong PO. Microbial quality, diversity and antibiotic susceptibility profiles of bacterial isolates from borehole water used by schools in Greater Giyani Municipality, Mopani District, South Africa. Afr J Microbiol Res. 2011;5(3):198-210.
-
Mwajuma JJ. Physico-Chemical and bacteriological quality of water, and antimicrobial susceptibility of pathogenic isolates from selected water sources in Samburu South,”a thesis submitted in partial fulfillment of the requirements for the award of the degree of master of science (Microbiology) in the school of pure and applied sciences, department of plant and microbial sciences, Kenyatta University; 2010. p. 8-90.
-
Marathe NP, Pal C, Gaikwad SS, Jonsson V, Kristiansson E, Larsson DGJ. Untreated urban waste contaminates Indian river sediments with resistance genes to last-resort antibiotics. Water Res. 2017;124:388-97. doi: 10.1016/j.watres.2017.07.060, PMID 28780361.
-
Mezrioui N, Baleux B. Resistance patterns of E. coli strains isolated from domestic sewage before and after treatment in both aerobic lagoon and activated sludge. Water Res. 1994;28(11):2399-406. doi: 10.1016/0043-1354(94)90056-6.
-
Feachem RG. Interventions for the control of diarrhoeal diseases among young children: promotion of personal and domestic hygiene. Bull World Health Organ. 1984;62(3):467-76. PMID 6331908.
-
Mari L, Casagrandi R, Rinaldo A, Gatto M. Epidemicity thresholds for water-borne and water-related diseases. J Theor Biol. 2018;447:126-38. doi: 10.1016/j.jtbi.2018.03.024, PMID 29588168.
-
Center for Disease Control (CDC). Antibiotic resistance questions and answers [Are antibacterial-containing products (soaps, household cleaners, etc.) better for preventing the spread of infection? Does their use add to the problem of resistance?]". Atlanta: Centers for Disease Control and Prevention; 2009. http://www.cdc.gov/getsmart/antibiotic-use/anitbiotic-resistance.
-
Collee AG, Fraser BP, Marmion, Simmons. A editors. Mackie and McCartney practical medical microbiology. 14th ed JG, editor; 2000.
-
World Health Organization. Diarrhoeal disease fact sheet; 2016. Available from; http://www.who.int/mediacentre/factsheets/fs330/en. [Last accessed on 23 Feb 2023]
-
Sartory DP, Spies K, Lange B, Schneider S, Langer B. Evaluation of a most probable number method for the enumeration of Legionella pneumophila from potable and related water samples. Lett Appl Microbiol. 2017;64(4):271-5. doi: 10.1111/lam.12719, PMID 28117485.
-
Krupanidhi KVJR. Mechanism of groundwater pollution in village wells. J Geol Soc India. 1984;25(5):301-2.
-
Walsh C. Antibiotics: actions, origins, resistance. Washington, DC: ASM Press; 2003.
-
Bessong PO, Odiyo JO, Musekene JN, Tessema A. Spatial distribution of diarrhoea and microbial quality of domestic water during an outbreak of diarrhoea in the Tshikuwi community in Venda, South Africa. J Health Popul Nutr. 2009;27(5):652-9. doi: 10.3329/jhpn.v27i5.3642, PMID 19902801.
-
Sandhu R, Dahiya S, Sayal P. Evaluation of multiple antibiotic resistance (MAR) index and doxycycline susceptibility of Acinetobacter species among inpatients. Indian J Microbiol Res. 2016;3(3):299-304. doi: 10.5958/2394-5478.2016.00064.9.